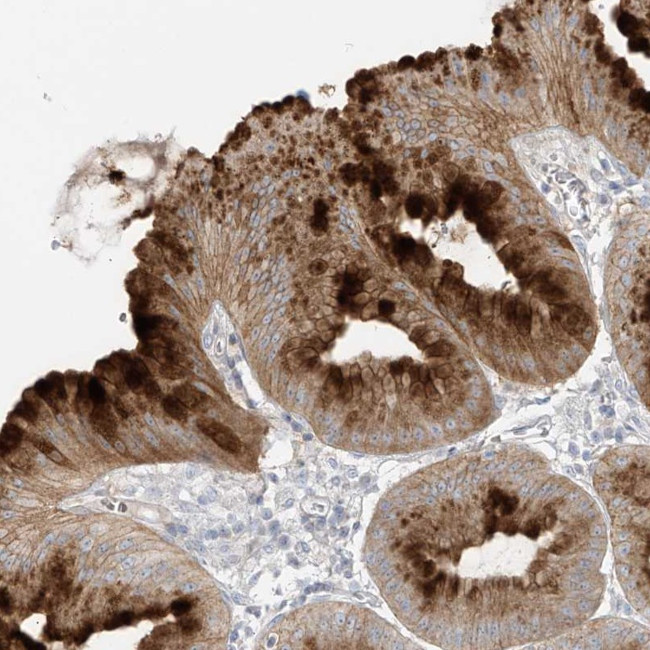
DGKQ Antibody in Immunohistochemistry (Paraffin) (IHC (P))

Search
Invitrogen
DGKQ Polyclonal Antibody
{{$productOrderCtrl.translations['antibody.pdp.commerceCard.promotion.promotions']}}
{{$productOrderCtrl.translations['antibody.pdp.commerceCard.promotion.viewpromo']}}
{{$productOrderCtrl.translations['antibody.pdp.commerceCard.promotion.promocode']}}: {{promo.promoCode}} {{promo.promoTitle}} {{promo.promoDescription}}. {{$productOrderCtrl.translations['antibody.pdp.commerceCard.promotion.learnmore']}}
产品信息
PA5-55422
种属反应
宿主/亚型
分类
类型
抗原
偶联物
形式
浓度
规格
纯化类型
保存液
内含物
保存条件
运输条件
RRID
产品详细信息
Immunogen sequence: HVSLFVGGLP PGLSPEEYSS LLHEAGATKA TVVSVSHIYS SQGAVVLDVA CFAEAERLYM LLKDMAVRGR LLTALVLPDL LHAKLPPDSC PLLVFVNPKS G
Highest antigen sequence identity to the following orthologs: Mouse - 82%, Rat - 84%.
靶标信息
Diacylglycerol (DAG) is a fundamental lipid second messenger that is produced in the nucleus. The accumulation of DAG in the nucleus is important for the regulation of cell growth and differentiation. Diacylglycerol kinases (DGKs) convert DAG to phosphatidic acid, thereby terminating diacylglycerol signaling, which results in the reduction of protein kinase C activity and cell cycle progression of T lymphocytes. Diacylglycerol kinases are divided into five subtypes, Type I-Type V. DGK-theta is a Type V DGK, and localizes mainly to the nucleus of various cell lines, such as MDA-MB-453, MCF-7, PC12 and HeLa. Nuclear DGK-theta co-localizes with phosphatidylinositol 4, 5-bisphosphate (PIP(2)). DGK-theta is the isoform responsive to alpha-Thrombin stimulation.
仅用于科研。不用于诊断过程。未经明确授权不得转售。
篇参考文献 (0)
生物信息学
蛋白别名: DAG kinase theta; DGK-theta; DGKtheta; Diacylglycerol kinase theta; diacylglycerol kinase, theta 110kDa; Diglyceride kinase theta; testis tissue sperm-binding protein Li 38a
基因别名: DAGK; DAGK4; DAGK7; DGKQ
UniProt ID: (Human) P52824
Entrez Gene ID: (Human) 1609